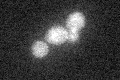
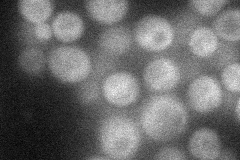
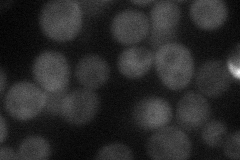
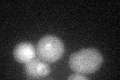
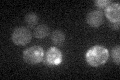

View description
Subunit of TORC2 (Tor2p-Lst8p-Avo1-Avo2-Tsc11p-Bit61p), a membrane-associated complex that regulates actin cytoskeletal dynamics during polarized growth and cell wall integrity; involved in sphingolipid metabolism; contains a RasGEFN domain
Localization:
Intensity:
Fold change:
Significance:
-
C’ GFP library in SD
cytosol21.93 -
N' NOP1pr-GFP in SD
cytosol31.8665 -
N' TEF2pr-mCherry in SD
cytosol25.7602 -
N' NATIVEpr-GFP in SD

below threshold19.3682 -
N' TEF2pr-VC and Cyto-VN in SD

cytosol29.9476 -
C’ GFP library in SD+DTT
cytosol20.180.92No -
C’ GFP library in SD+H2O2

cytosol24.131.1No -
C’ GFP library in Starvation Media
cytosol19.460.88No -
C’ GFP library on the background of Pup2-DaMP

cytosol -
C’ GFP library on the background of CCT mutant

cytosol23.57921.0747No
